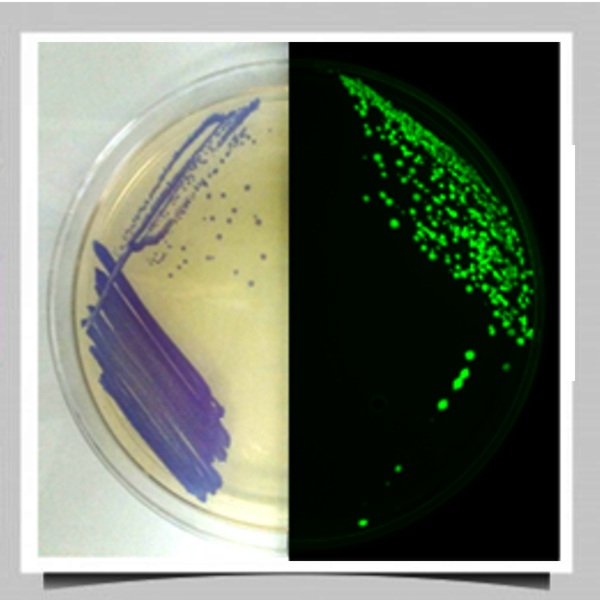

El cuerpo académico consolidado BIOLOGÍA CELULAR Y MOLECULAR DE MICROORGANISMOS PATÓGENOS DE INTERÉS BIOMÉDICO se formó en el año 2002 y está adscrito al Departamento de Biología de la Universidad de Guanajuato, ubicado en el Campus Guanajuato. Los nombres de los profesores investigadores que forman parte de este cuerpo académico, se muestran enlistados en el orden en que aparecen en la foto
Dr. Dra. Patricia Nayeli A. Murillo
pn.alva@ugto.mx
Dr. Bernardo F. Bárcenas
bfranco@ugto.mx
Dr. Luis Felipe P. Vaca
padillaf@ugto.mx
Dra. Patricia C. Mata
mata@ugto.mx
Dra. Ruth Reyes Cortés
reyes.ruth@ugto.mx
Líneas de generación del conocimiento
Nuestro Cuerpo Académico centra sus intereses en la investigación alrededor de dos líneas de generación y aplicación del conocimiento, que son:
- La patobiología de microorganismos; es decir, estudiamos los procesos y moléculas que algunos agentes patógenos del ser humano emplean como mecanismos de agresión para causar infecciones.Particularmente nuestra investigación se ha enfocado hacia los mecanismos de patogenicidad de los parásitos Entamoeba histolytica (amibas) y Trichomonas vaginalis.
¿Por qué?
1. En nuestro país, la Entamoeba histolytica es la sexta causa entre las enfermedades transmisibles y debido a que la amibiasis es una enfermedad diarreica, contribuye a la desnutrición infantil.
2. La Monas Vaginalis es la doceava causa de enfermedades infecciosas en México; además, la tricomoniasis incrementa el riesgo de sufrir otras enfermedades genitourinarias y el riesgo de parto prematuro en mujeres embarazadas. - La Inmunobiología de microorganismos patógenos, en esta área nos interesa comprender los mecanismos que participan en la defensa de manera inmediata; es decir, la respuesta inmune innata y su efectividad contra los parásitos mencionados: Entamoeba histolytica y Trichomonas vaginalis.


L1 Patobiología de microorganismos
Patobiología de los microorganismos.
E. histolytica posee una serie de moléculas denominadas factores de virulencia que utiliza para atacar y defenderse del hospedero. Sin embargo, este parásito también posee moléculas que están indirectamente involucradas en el proceso patogénico denominadas determinantes de virulencia que le confieren una alta plasticidad metabólica favoreciendo su adaptación y supervivencia, tales como las esfingomielinasas, GTPasas, etc.
El parásito Entamoeba histolytica, el agente causal de la enfermedad diarreica llamada amibiasis, posee una enzima con estructura y actividad enzimática similar a la de la toxina diftérica. En este “proyecto”, deseamos determinar si la enzima de la amiba similar a la toxina de la difteria modifica alguna proteína en células humanas. Estos datos arrojarán evidencias sobre su probable función y sería la primera toxina descubierta en un parásito que pertenece a la familia de las toxinas bacterianas.

Mecanismos moleculares que regulan la modulación de la virulencia de Entamoeba histolytica
Búsqueda de nuevos factores y determinantes de virulencia de E. histolytica
- Esfingomielinasas: Enzimas multifuncionales implicada en la modulación de la virulencia de E. histolytica.
- GTPasas: Interruptores moleculares implicados en la virulencia amibiana
- Implementación de herramientas moleculares para descubrir nuevas moléculas implicadas en el proceso patogénico.
- Implementación de herramientas moleculares para descubrir nuevas moléculas implicadas en el proceso patogénico.
- Proteínas de Entamoeba histolytica con estructura y actividad enzimática similar a la toxina de la difteria


Efecto de diferentes componentes del hospedero sobre la virulencia de Trichomonas vaginalis
L2 Inmunobiología de microorganismos patógenos
Inmunobiología de microorganismos patógenos
En esta línea de investigación nos interesa analizar la respuesta inmune innata; es decir, los mecanismos de defensa del organismo que actúan de manera inmediata ante la llegada de un patógeno. Éstos incluyen varias estrategias de defensa contra Entamoeba histolytica y Trichomonas vaginalis; entre ellas participan células fagocíticas humanas como neutrófilos y macrófagos y los denominadas péptidos antimicrobianos.
Los neutrófilos por ejemplo, atrapan al parásito en una especie de trampas formadas de ADN y péptidos antimicrobianos, lo cual disminuye la viabilidad de los patógenos.
También nos interesa entender los mecanismos de comunicación celular que tienen lugar entre las propias células de defensa a través de la producción de citocinas, compuestos que inducen la llegada de los diversos tipos celulares del hospedero y nuevas estrategias de defensa ante el reconocimiento de los componentes del patógeno. En este proyecto manejamos líneas celulares y modelos murinos de infección con tricomonas.

Interacción de neutrófilos y macrófagos humanos con E. histolytica y T. vaginalis
Interacción del peptido LL-37 con amibas
Efecto de péptidos antimicrobianos contra E. histolytica y T. vaginalis


Exosomas
Inmunomodulación de la respuesta immune por exosomas y DNA del parásito T. vaginalis
Poblaciones celulares que participan en la defensa contra T. vaginalis

Estrategias para combatir a los microorganismos de interés biomédico
Preocupados por la falta de tratamientos.
Otros temas de investigación relacionados con la biología celular y molecular de los microorganismos involucra el estudio de alternativas para combatir a los microrganismos patógenos de interés biomédico. Entre estas estrategias, este cuerpo académico estudia las siguientes:
- Nanocompuestos que son polímeros naturales (quitosano) y sintéticos <(Nylon) asociados a nanopartículas de Cu y Ag.
- Péptidos naturales antimicrobianos: como los derivados de la lactoferrina y la catelicidina humana LL-37 que presentan actividades microbicidas
- Compuestos de origen natural modificados químicamente para potenciar sus propiedades antimicrobianas
- Ácidos grasos orgánicos con propiedades inmunomoduladoras y antimicrobianas.
- Bacteriófagos: específicamente bacteriófagos líticos, que al ser capaces de lisar a su bacteria huésped, pueden ser utilizados como alternativa de tratamiento de las infecciones bacterianas.
- Biosensores bacterianos: Los biosensores son dispositivos acoplados a un módulo biológico que permite determinar un analito específico. Nuestro grupo está interesado en el desarrollo de biosensores de célula completa que permitirán analizar el daño celular causado por nanomateriales y nanopartículas, así como compuestos antimicrobianos y conocer su mecanismo de acción. También permitirá el desarrollo de sistemas de detección de xenobióticos de relevancia ambiental de manera rápida y de bajo costo.

Compuestos antimicrobianos
Compuestos de origen natural modificados químicamente con propiedades antimicrobianas.
Nanopartículas
Nanocompuestos naturales o sintéticos asociados con nanopartículas metálicas con propiedades antimicrobianas


Compuestos de origen natural modificados químicamente con propiedades antimicrobianas
Ácidos grasos orgánicos con propiedades inmunomoduladores y antimicrobianas
Bacteriòfagos
Los bacteriófagos son virus que infectan bacterias de forma especifica y pueden ser utilizados como alternativa de tratamiento en infecciones bacterianas.

Biosensor
Biosensores bacterianos para la caracterización de mecanismos de acción microbicidas
Instituciones de colaboración













